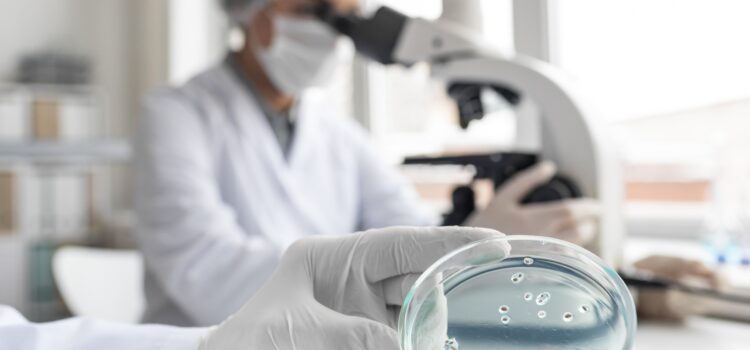
Xét nghiệm Vi sinh – Tổng quan về Vai trò, Quy trình và Ý nghĩa trong Y học hiện đại Xét nghiệm Vi sinh – Tổng quan về Vai trò, Quy trình và Ý nghĩa trong Y học hiện đại

https://www.youtube.com/watch?v=O9NKJCad08k Nhân dịp kỷ niệm 10 năm thành lập (25/11/2015 – 25/11/2025), Tập thể Cán bộ Nhân viên Công ty TNHH Giải Pháp Thiên Phúc Hưng (TPH Solutions) đã có chuyến đi Team Building tại Cồn Sơn – một nơi
Chuyến đi Team Building – Kỷ niệm 10 năm thành lập – Hành trình cùng Đồng hành và Phát triển